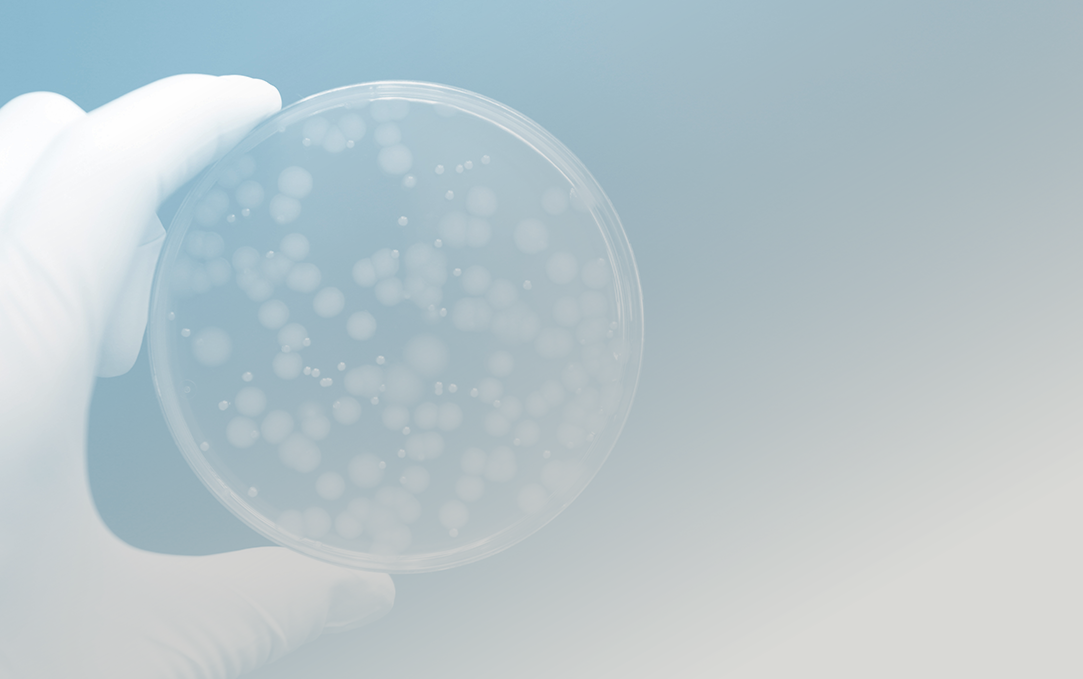

Never Worry About Your Well Water Again
Have a question? call us now
+1 (301) 942.0402
We are open Mon - Fri
Mon - Fri 09:00 - 17:00
Order the service by mail
hello@aquafeelmaryland.com
WHY INSTALL AN AQUAFEEL SYSTEM ?
LIFETIME WARRANTY
When you install our system, you become part of our family for life. Our team of experts is just one call away for any technical issues you might have.
VORTECH TECHNOLOGY
We use the world’s most innovative and efficient water treatment system. Vortech technology removes more contaminants than other systems and increases your water performance.
Free Installation
Don’t worry about installation or other hidden costs. We send a water specialist to your home to complete installation and ensure your system is in optimal working order.
5.500 +
Customer Trusted
WHAT IS INCLUDED?
The Aquafeel Well Water System ensures a consistent and safe drinking water supply from your well. To guarantee the quality of your well water, we use additional, state-of-the-art equipment:
It’s Simple!
1
Book a consultation
Click on the “Book a consultation” button, fill out the form, and one of our analysts will contact you to make an appointment.
2
Set up Installation
Use our interactive calendar or an Aquafeel representative will reach out to determine the most convenient time for you.
3
Enjoy pure water
Sit back and let the system work for you. Rest assured knowing you have clean, pure water from every faucet in your home.
HOW DOES IT WORK?
WELL WATER TREATMENT

FILTER HOUSING
Big Blue filter housings offer the versatility to meet all of your high capacity filtration needs, including high flow and heavy sediment applications. Reduces sand, dirt, sediment particles, rust, and scale in residential and commercial water. Removes large and fine particles from drinking water, such as sand, dirt, silt, and rust.

RUSCO SEDIMENT TRAPPER
RUSCO Model Rotary Sediment Filters with Polyester Screens make solid particle removal simple and inexpensive. The benefit of the Spin-Down filter is its cleaning and reuse capacity. The unique design of the sediment trapping element allows debris to settle to the bottom of the clear cover, trapping sediment from the screen.

ULTRAVIOLET
KDF premium provides protection against the growth of bacteria, water-borne viruses, and mold while the filter is stored or not in use.

REVERSE OSMOSIS
Reverse Osmosis (RO) is a water treatment process that removes contaminants from water by using pressure to force water molecules through a semipermeable membrane. During this process, the contaminants are filtered out and flushed away, leaving clean, delicious drinking water.
Our Certifications









POTENTIAL WELL WATER CONTAMINANTS
Microorganisms
Include bacteria, viruses, and parasites. People that consume drinking water containing microorganisms can experience gastrointestinal illnesses and infections.

Heavy Metals
Can leach into drinking water from household plumbing and service lines, mining operations, petroleum refineries, electronics manufacturers. Heavy metals include: arsenic, antimony, cadmium, chromium, copper, lead, selenium and many more.

Nitrate And Nitrite
Present in chemical fertilizers, human sewage, animal waste and fertilizers. They can contaminate a private well through groundwater movement, surface water seepage, and water run-off. High levels of nitrates/nitrites in drinking water can cause methemoglobinemia or “blue baby syndrome.”

Organic Chemicals
Found in many house-hold products and widely used in agriculture and industry. People that consume high levels of organic chemicals may suffer from damage to their kidneys, liver, circulatory system, nervous system, and reproductive system.

Radionuclides
Can contaminate private wells through groundwater flow, waste water seepage and flooding. Drinking water with radionuclides can cause toxic kidney issues and increase the risk of cancer.

Fluoride
Present in many aquifers and can be found in private wells. Fluoride can be helpful in preventing tooth decay. However, excessive consumption of fluoride can cause skeletal fluorosis, a condition characterized by pain and tenderness of bones and joints.
Get a water test today!
Unsafe Levels of Contaminants in Your Drinking Water Can Have Devastating Effects on Your Health.




